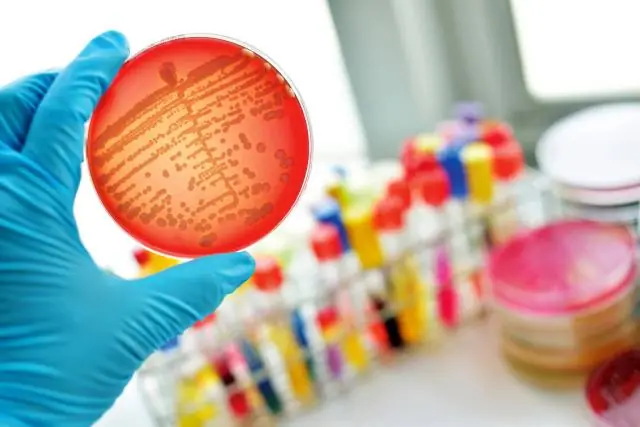
Новый класс антибиотиков для борьбы с лекарственной устойчивостью: недавно открытый антибиотик связывается с рибосомой, нарушая синтез белка

Исследователи из Иллинойского университета в Чикаго и Nosopharm, биотехнологической компании, базирующейся в Лионе, Франция, являются частью международной группы, сообщающей об открытии нового класса антибиотиков.
Антибиотик, впервые идентифицированный Нозофармом, уникален и многообещающ по двум направлениям: его нетрадиционный источник и особый способ уничтожения бактерий, оба из которых предполагают, что соединение может быть эффективным при лечении лекарственно-устойчивых или трудно поддающихся лечению -лечить бактериальные инфекции.
Называемые одилорхабдинами, или ODL, антибиотики вырабатываются симбиотическими бактериями, обитающими в почвенных червях-нематодах, которые колонизируют насекомых в пищу. Бактерии помогают убить насекомое и, что важно, выделяют антибиотик для защиты от конкурирующих бактерий. До сих пор эти связанные с нематодами бактерии и антибиотики, которые они производят, были в значительной степени недостаточно изучены.
Чтобы идентифицировать антибиотик, исследовательская группа Nosopharm провела скрининг 80 культивируемых штаммов бактерий на антимикробную активность. Затем они выделили активные соединения, изучили их химическую структуру и разработали более сильнодействующие производные.
Исследование, опубликованное в журнале Molecular Cell, впервые описывает новый антибиотик и то, как он работает.
Соавторы UIC Александр Манкин и Юрий Поликанов являются авторами-корреспондентами исследования и руководили исследованием механизма действия антибиотика. Они обнаружили, что ODL действуют на рибосому - молекулярную машину отдельных клеток, которая производит белки, необходимые для ее функционирования, - бактериальных клеток.
«Как и многие клинически полезные антибиотики, ODL воздействуют на рибосомы, - сказал Поликанов, доцент кафедры биологических наук Колледжа свободных искусств и наук UIC, - но ODL уникальны, потому что они связываются с местом на рибосоме. рибосома, которая никогда не использовалась другими известными антибиотиками».
Исследователи UIC, в том числе аспирантка Таня Флорин и научный сотрудник с докторской степенью Малгожата Добош-Бартошек, также обнаружили, что при связывании с рибосомой антибиотик нарушает ее способность интерпретировать и транслировать генетический код.
«Когда ODL вводятся в бактериальные клетки, они влияют на способность считывания рибосомы и заставляют рибосому совершать ошибки при создании новых белков», - сказал Манкин, директор Центра биомолекулярных наук в UIC. Колледж фармации. «Это неправильное кодирование портит клетку дефектными белками и приводит к гибели бактериальной клетки."
Хотя многие антибиотики могут замедлять рост бактерий, Манкин говорит, что антибиотики, которые действительно убивают бактерии, называемые бактерицидными антибиотиками, встречаются редко.
«Бактерицидный механизм ODL и тот факт, что они связываются с участком на рибосоме, который не используется ни одним из известных антибиотиков, являются очень убедительными индикаторами того, что ODL обладают потенциалом для лечения инфекций, которые не поддаются лечению другими антибиотиками», - сказал Манкин, который также является профессором медицинской химии и фармакогнозии.
По данным Всемирной организации здравоохранения, устойчивость к антибиотикам является одной из самых серьезных угроз для глобального здравоохранения сегодня и в значительной степени способствует увеличению продолжительности пребывания в больнице, увеличению медицинских расходов и увеличению смертности.
Во Франции исследователи Nosopharm протестировали соединения ODL против бактериальных патогенов, в том числе против многих, у которых, как известно, развивается резистентность.
«Мы обнаружили, что соединения ODL вылечили мышей, инфицированных несколькими патогенными бактериями, и продемонстрировали активность как против грамотрицательных, так и против грамположительных патогенов, особенно в том числе устойчивых к карбапенемам Enterobacteriacae», - сказал соавтор Максим Гуалтьери, соавтор -основатель и главный научный сотрудник Нозофарм.
Устойчивые к карбапенемам энтеробактерии, или CRE, представляют собой семейство микробов с высоким уровнем устойчивости к антибиотикам. Одно исследование предполагает, что CRE, которые являются общими виновниками инфекций кровотока и хирургических вмешательств, способствуют смерти в до до 50 процентов инфицированных пациентов.
Исследователи говорят, что это исследование является свидетельством растущей тенденции международного и междисциплинарного сотрудничества, которое необходимо для борьбы с растущей глобальной угрозой устойчивости к антибиотикам.
В данном случае объединенный опыт отрасли, у которой есть ресурсы для разработки новых соединений, и научных кругов, у которых есть исследовательские и лабораторные возможности для понимания того, как работают соединения, позволили разработать этот новый класс антибиотиков», - сказал Манкин.
«Сотрудничество между несколькими лабораториями с разными областями знаний повышает доверие к исследованиям», - сказал Поликанов.
Хотя ODL еще предстоит тщательно изучить на предмет их терапевтического потенциала, исследователи говорят, что результаты исследования оправдывают будущие исследования в этом направлении.
"Сотрудничество с академическими кругами с известными экспертами в области антибиотиков, такими как команда UIC, помогает нам в этой доклинической разработке", - сказал Филипп Виллан-Гийо, соучредитель и главный исполнительный директор Nosopharm.
В исследовании, финансируемом Nosopharm, участвуют Люсиль Пантель, Эмили Расин, Матье Сарсьо, Марин Серри, Джессика Уар и Андре Амелас из Nosopharm; Жан-Марк Кампань, Рената Марсия де Фигейредо и Камиль Мидрье из Института Шарля Герхардта Монпелье в Монпелье, Франция; Софи Годрио, Ален Живодан и Анн Лануа из Университета Монпелье в Монпелье, Франция; Стив Форст из Висконсинского университета в Милуоки, штат Висконсин; Кристель Котто-Лотар и Жан-Мишель Болла из Экс-Марсельского университета в Марселе, Франция; Carina Vingsbo Lundberg из Государственного института сывороток в Копенгагене, Дания; и Дуглас Хасби и Диармейд Хьюз из Упсальского университета в Уппсале, Швеция.